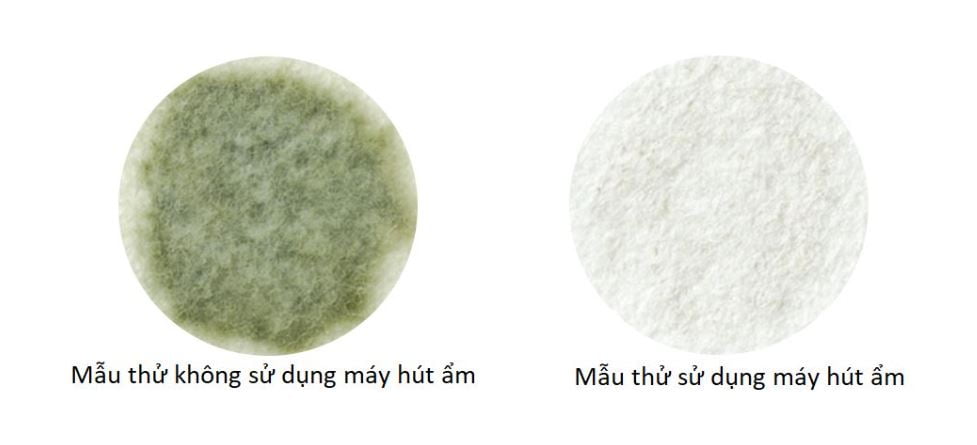
Máy hút ẩm Mitsubishi MJ-180YX-W

Máy hút ẩm Mitsubishi MJ-180YX-W
Máy hút ẩm Mitsubishi MJ-P180YX-W dòng hút ẩm chân voi nội địa Nhật
Tình trạng: Hàng mới 100%
Điện áp: 100V
Kích thước: 594 x 372 x 281 mm ( cao x rộng x sâu)
Tính năng:
Công nghệ Inverter tiết kiệm điện
Hút ẩm trong không khí
Loại bỏ vi khuẩn – nấm mốc
Hút 18L nước / ngày công nghệ Block
Sấy quần áo
Cảm biến nhiệt độ / độ ẩm
Tự động hoạt động lại khi mất điện
9.700.000 ₫ 10.200.000 ₫
Máy hút ẩm Mitsubishi MJ-P180YX-W là model máy hút ẩm chân voi sử dụng cho phòng 30-75m² được sản xuất và sử dụng cho thị trường nội địa Nhật, ra mắt vào tháng 10 năm 2025 sử dụng công nghệ hút bằng máy nén (block) và có các cảm biến thông minh 3D, nhận diện vùng ẩm, cân bằng độ ẩm. Máy hút ẩm hiệu quả, nhanh, không sinh nhiệt, hoạt động siêu êm, tiết kiệm điện năng tiêu thụ. Nhiều chức năng hút ẩm khác nhau cho từng độ ẩm và thời tiết. Đặc biệt máy có tính năng sấy khô quần áo, hoạt động kháng khuẩn và nấm mốc đem lại bầu không khí sạch và cân bằng độ ẩm phù hợp cho mọi không gian sử dụng.

Tính năng nổi bật:
Máy hút công suất lớn 18L/ngày
Công nghệ hút bằng máy nén
Hoạt động êm, không sinh nhiệt, tiết kiệm điện
Hiển thị màn hình, dễ nhìn và dễ dàng sử dụng
Nhiều chức năng phù hợp với nhiều địa hình nhà, thời tiết
Hút ẩm hiệu quả, nhanh
Cân bằng độ ẩm
Cảm biến thông minh, nhận diện vùng ẩm
Có chức năng sấy quần áo
Có bánh xe di chuyển dễ dàng hơn
Hút ẩm với công suất lớn nhất 18L / ngày (ở 60Hz)
Với công suất hút cao, máy hoạt động hút ẩm nhanh chóng cho diện tích phòng tói đa đến 75m², chính vì thế, với chiếc máy hút ẩm này bạn có thể sử dụng cho mọi không gian nhà của mình mà không cần lo lắng về diện tích.
Ngoài ra, cánh gió thổi phía dưới có thể hút ẩm triệt để nệm futon, thảm và sàn nhà.
Phương pháp máy nén(block) được áp dụng thực hiện khả năng hút ẩm mạnh mẽ quanh năm.
Được trang bị bộ lọc ba rào cản
Đây là thiết kế mới được sử dụng ở model hút ẩm chân voi MJ-P180YX-W, bộ lọc có tác dụng ngăn chặn vi rút, vi khuẩn và các chất gây dị ứng trôi nổi trong không khí. Ngoài ra, nó còn được trang bị bộ lọc kháng khuẩn bằng bạch kim, cho phép bạn làm sạch và hút ẩm và làm khô trong phòng sạch.
Bộ lọc ba rào cản là bộ lọc cố định hóa học các enzym nhân tạo (chống dị ứng, kháng khuẩn, ngăn chặn vi rút) vào sợi rayon.

Với tính năng loại bỏ vi khuẩn, nấm mốc, dị ứng, việc sử dụng thiết bị này cho phòng tắm cũng rất hợp lí và cần thiết
Vào mùa đông, khi sử dụng nước nóng, ấm trong không gian phòng tắm, hơi nước gặp bề mặt có nhiệt độ thấp như gương, kính, cửa, sàn,… sẽ ngưng tụ và với không gian đặc thù phòng tắm thì đây là môi trường lí tưởng để vi khuẩn, nấm mốc sinh sôi. Lượng hơi nước này ngưng tụ cũng gây nên hư hại về bề mặt bằng gỗ.
Mitsubishi MJ-P180YX với các cảm biến thông minh tự động tìm nước và và hơi ẩm ngưng tụ trên sàn, tường và trần trong phòng tắm giúp bạn làm khô hoàn toàn, giúp kìm hãm sự phát triển của nấm mốc gây bệnh.

Mitsubishi đã nghiên cứu sử dụng một mẫu thử (cảm biến nấm mốc) có chứa các bào tử của cladosporium (nấm mốc đen), nhiệt độ phòng được giữ ở 20 ° C và độ ẩm ở 90% và khi nhiệt độ phòng được giữ ở 20 ° C và độ ẩm ở 90% trong 20 giờ và độ ẩm 50% trong 4 giờ. Kết quả giảm đến 80% lượng vi khuẩn và nấm mốc sinh sôi.
Chức năng sấy khô quần áo
Với khả năng hút ẩm công suất cao máy làm khô một lượng lớn đồ giặt một cách chắc chắn và nhanh chóng.

Bình chứa nước dung tích lớn, hoặc có thể xử lí thoát nước liên tục

Nếu bạn kết nối một ống dẫn và xả nước, bạn có thể hút ẩm liên tục mà không gặp rắc rối khi phải đổ bỏ nước trong bình chứa rất thích hợp để chống nấm mốc trong phòng tắm, những chuyến đi xa, hút ẩm biệt thự, v.v.

Hoạt động làm sạch bên trong thân máy
Bằng cách làm khô hơi ẩm bên trong, thiết bị chính sẽ được làm sạch. Thời gian làm sạch khoảng 1 giờ. Bạn có thể nhấn vệ sinh ngay cả khi thiết bị đang hoạt động.

Chức năng hoạt động lại khi gặp sự cố mất điện
Chức năng khôi phục sự cố mất điện được cài đặt trong tất cả các dòng ở MJ-P180TX cũng vậy, ngay cả khi mất điện, nó sẽ tiếp tục ở chế độ hoạt động ban đầu sau khi khôi phục! Có thể hút ẩm liên tục 24 giờ một ngày, 365 ngày một năm.
Bảng điều khiển dễ dàng sử dụng

Thông số kĩ thuật:
| Tên model | MJ-P180YX-W |
| Nhà sản xuất | Mitsubishi |
| Xuất xứ | Nhật Bản |
| Điện áp | 100V |
| Công suất tiêu thụ | 330-390W |
| Công suất hút | 18L/ngày |
| Phương pháp hút ẩm | Máy nén không sinh nhiệt |
| Cảm biến | Cảm biến độ ẩm, nhiệt độ |
| Hướng gió | Cánh đảo gió tự động góc rộng, cánh hướng gió thổi xuống |
| Hẹn giờ bắt/bật | 1-9 |
| Diện tích sử dụng | 30-75m² |
| Dung tích bình chứa | 4,7L |
| Kích thước | Cao 594 x Rộng 372 x Sâu 281mm |
| Khối lượng | 14,9kg |
| Chiều dài dây dẫn | 1,8m |




























![[cata list] Thiết bị theo mùa 2 Máy Hút Ẩm](https://www.kanto.vn/wp-content/uploads/2022/11/hut-am-mitsubishi-chan-voi-nhat.png)
![[cata list] Thiết bị theo mùa 3 Máy Lọc Không Khí Nhật](https://www.kanto.vn/wp-content/uploads/2022/11/may-loc-khong-khi-nhat.png)
![[cata list] Thiết bị theo mùa 5 Điều Hoà Nhật - Máy Lạnh Nhật Giá Tốt](https://www.kanto.vn/wp-content/uploads/2022/11/dieu-hoa-noi-dia-nhat-panasonic-1.png)
![[cata list] Thiết bị theo mùa 6 Quạt Điện Nhật](https://www.kanto.vn/wp-content/uploads/2022/11/quat-dien-panasonic-nhat.png)





Chưa có đánh giá nào.